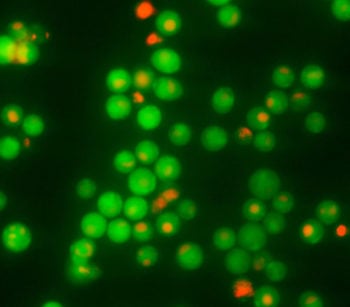
product-image-AAA52740_AD13.jpg

2. If storing the stock concentrate for future use, prepare small aliquots (20 ?L) to avoid freeze-thaw cycles. The stock concentrate will be stable for 6 months when protected from light and stored at or below -20°C.
3. Create the 10X working solution by diluting the 2500X stock solution 1:250 in sterile PBS; e.g., add 4 ?L stock to 996 ?L PBS. Store the working solution on ice up to 2 hours protect-ed from light. Do not use media to dilute the CFSE as it will quench the fluorescent signal!
4. Prepare cells at 1-2 x 107 in 1.8 mL sterile PBS.
5. Create 1 control tube of unstained cells at 1-2 x 107 in 2 mL sterile PBS. These cells will be used to compensate the flow cytometer to ensure that stained cells shift along the FL1 axis. In Figure 1, FL1 is shown on the X-axis and stained cells shiftto the right compared with unstained cells.
6. Stain cells at a final concentration of 0.1 ?g/mL (0.18 ?M) of CFSE in the cell culture. Add the 10X working solution to the cells at a dilution of 1:10. For example, add 200 ?L 10X CFSE working solution into 1.8 mL cell suspension. Mix by invert-ing or vortexing the vial. The optimal concentration of CFSE may vary among cell types. Each investigator should adjust the concentration and incubation time to accommodate the particular cell line and research conditions. Excessive staining may cause problems when compensating the instrument. Do not add CFSE to the control tube.
7. Incubate 15 minutes at room temperature.
8. Add 1 mL cell culture media to stop the reaction.
9. Incubate 5 minutes.
10. Wash the cells once or twice by centrifugation and discard the supernatant.
11. Resuspend in cell culture media such that each tube contains the desired level of target cells, or resuspend in PBS and fix cells with formaldehyde.
12. Analyze cells, or incubate at 37°C up to 1 hour until ready for additional staining or further experimentation.
13. Analyze with a flow cytometer equipped with a 15 mW 488 nm argon laser: excitation at 492 nm; emission at 520-540 nm in FL1. Stained cells appear green.
Application Data
(As CFSE is detected in the green range, it is optimal for use in dual-staining studies with other fluorescent reagents with minimal spectral overlap. In this experiment, K562 target cells were stained green with CFSE to distinguish them from eff ector cells in FL1 (Figure 2). The target cells were stained with 7-AAD to identify membrane-compromised necrotic target cells (red in FL3), and with SR-FLICA® to identify caspase-positive apoptotic target cells (orangy-red in FL2). When used together, these reagents identified four populations of cells: live; early apoptotic; late apoptotic; and necrotic leading to more accurate results when assessing cell death.)
Application Data
(In this experiment, K562 target cells were stained green with CFSE and then subjected to eff ector cells. Green stained target cells are easily iden-tifiable when analyzed by FL1 vs. SSC on a flow cytometer. Target cells stained green with CFSE move to the right along the X-axis (FL1) of the plot (right) compared with unstained eff ector cells. This plot becomes particularly important when gating on target cells that are the same size as eff ector cells.)
Application Data
(Healthy Jurkat cells were stained with CFSE or were unstained and then analyzed by flow cytometry using an Accuri C6 flow cytometer equipped with a FL1 99% attenuation filter. Unstained Jurkat cells are shown in the left-most histogram below (A.), and stained Jurkat cells are shown in the middle histogram (B.). An overlay of the two populations is shown in the right-most histogram (C.))
CFSE diffuses into the cell and covalently binds to primary amino groups present on intracellular molecules. Intracellular esterases quickly cleave the acetate groups from the dye thus converting it to the fluorescent form. Any unbound reagent diff uses back out of the cell. Because CFSE forms a strong bond inside the cell, it is retained within the cell indefinitely and is inherited by daughter cells. It will not be incorporated into adjacent cells.
CFSE is supplied as a concentrated lyophilized powder at 0.05 mg. Reconstitute it with 200 ?L DMSO to yield a stock concentrate at 2500X (0.25 mg/mL). Dilute it 1:250 in PBS to form the 10X working solution, and then add it to cells at 1:10 (a final concentration of 0.1 ug/mL). Analyze with a fluorescence microscope or flow cytom-eter with a 488 nm blue argon excitation laser. CFSE exhibits green fluorescence in the FL1 region: excitation at 492 nm and emission at 520-540 nm (Figures 1-3).
As CFSE is detected in the green range, it is optimal for use in dual-staining studies with other fluorescent reagents, such as PI (MBS258060), 7-AAD (MBS258053), and SR-FLICA® with minimal spectral overlap. Use it with ICT’s SR-FLICA poly caspases inhibitor reagent to identify apoptotic cells in the analysis (Figure 3).
Customer Reviews
Loading reviews...
Share Your Experience
Similar Products
Product Notes
The CFSE Fluorescent Cellular Stain (Catalog #AAA52739) is a Reagent and is intended for research purposes only. The product is available for immediate purchase. The immunogen sequence is How To Use||1. Reconstitute the vial of CFSE with 200 DMSO to create a 2500X stock concentrate at 0.25 mg/mL. Mix by swirling or tilting the vial, allowing the DMSO to travel around the base of the amber vial until completely dissolved. At room tem-peratu. It is sometimes possible for the material contained within the vial of "CFSE Fluorescent Cellular Stain, Reagent" to become dispersed throughout the inside of the vial, particularly around the seal of said vial, during shipment and storage. We always suggest centrifuging these vials to consolidate all of the liquid away from the lid and to the bottom of the vial prior to opening. Please be advised that certain products may require dry ice for shipping and that, if this is the case, an additional dry ice fee may also be required.Precautions
All products in the AAA Biotech catalog are strictly for research-use only, and are absolutely not suitable for use in any sort of medical, therapeutic, prophylactic, in-vivo, or diagnostic capacity. By purchasing a product from AAA Biotech, you are explicitly certifying that said products will be properly tested and used in line with industry standard. AAA Biotech and its authorized distribution partners reserve the right to refuse to fulfill any order if we have any indication that a purchaser may be intending to use a product outside of our accepted criteria.Disclaimer
Though we do strive to guarantee the information represented in this datasheet, AAA Biotech cannot be held responsible for any oversights or imprecisions. AAA Biotech reserves the right to adjust any aspect of this datasheet at any time and without notice. It is the responsibility of the customer to inform AAA Biotech of any product performance issues observed or experienced within 30 days of receipt of said product. To see additional details on this or any of our other policies, please see our Terms & Conditions page.Item has been added to Shopping Cart
If you are ready to order, navigate to Shopping Cart and get ready to checkout.